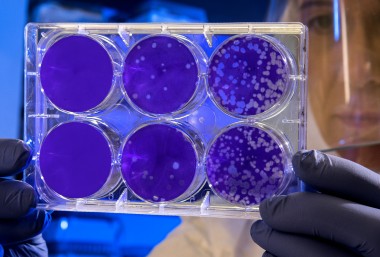

Celebrating International Day of Women and Girls in Science.
Did you know, our talented people aren’t just experts in the legal field. Many of them have also studied other subjects, such as science. While our people are experts in law, their in-depth scientific knowledge allows them to work closely with researchers in the public and private sectors to protect and commercialise innovation. Whether it be developing a new drug, a medical device, or plant variety, IP plays an important role in protecting these innovations and getting them to market.
To celebrate International Day of Women and Girls in Science, we spoke to Dr Nikki Templeton, Dr Briar Dominick and Dr Victoria Argyle who work at the intersection of science and law. All three have PhDs in scientific subjects and these women continue to make waves in the world of IP.

Why did you choose a career in science?
I always liked understanding how things work and why, especially the human body. I didn’t want to be a medical doctor, but loved studying human biology at school. Medical research was the area that drew my interest, and I was fascinated by how the brain was involved in so many complex processes. After finishing my PhD, I spent a few years working as a postdoctoral researcher, where I was involved in researching new therapeutics for multiple sclerosis. I loved the hands on work in a lab, but wanted to move out of academia so I joined AJ Park in 2020 as a patent executive.
Science is always changing and advancing, and I love that.
What do you enjoy most about your job?
I enjoy the process of being given a new area of science to work on from a patent perspective and having to quickly research and understand the background information and the scientific advancements that have been made. Science is always changing and advancing, and I love that. I also enjoy talking to clients about their inventions and research.
Why should girls and women consider a career in science?
You get to develop and use a huge range of skills - communication, hands on research, teaching, and critical thinking to name a few. These are skills that you can use in all parts of your life. Every day is different and making new discoveries or answering your research questions can be really satisfying.

Why did you choose a career in science?
I always enjoyed science at high school and it always “clicked” for me. I kept my options open for as long as possible at university and ended up studying a mixture of chemistry, pharmacology and biochemistry because that’s what interested me.
I worked a summer in a biofuel lab and nine months in a lab at a winery before starting my PhD. After that, I worked at the University of Auckland researching and teaching for three years before moving to AJ Park.
I get to see the broad range of research in
New Zealand and around the world and have a small part of it.
What do you enjoy most about your job?
I get to see the broad range of research happening in New Zealand and around the world and have a small part of it. The amount of innovation in this space is amazing, and it’s great to be able to support clients all over the world to protect and commercialise their important work.
What problems are you solving in your day-to-day role?
A phenomenal amount of work goes into researching and developing things that improve our lives. I help clients commercialise and protect their research in areas such as pharmaceuticals, food science, and biodegradable materials.
Why should girls and women consider a career in science?
Science affects everyone and everything. If you’re truly interested in science and solving the critical problems we face all over the world, then a career in science is for you.

Why did you choose a career in science?
My first chemistry teacher at Katikati College was a key reason I pursued chemistry at University. He recognised my ability in the subject and encouraged me to take it further after high school. However, I also loved history, English, and economics and, according to the careers book Katikati College produced, all three would be useful in the field of law.
I landed on studying law and science and during University I attended a seminar about a career as a patent attorney. I realised very quickly that this career would be the perfect opportunity for me to combine both my law and chemistry studies in the real world. It was also very clear to me that my science background was more impressive than my law background – one can be a patent attorney without ever studying law at University.
I am now a qualified patent attorney and employed as a senior associate in the litigation team at AJ Park. My science background means I am perfectly placed to assist in all patent-related litigious matters and I now find myself doing a lot of work for Fonterra. So, while my career in science was limited to my time at university, I have used my science knowledge throughout my career in law to assist clients in obtaining and maintaining/defending their patent rights.
I get to liaise with clients from around the world and immerse myself in their world of science and what they are passionate about.
What do you enjoy most about your job?
The fact that I am constantly learning about new areas of science. Chemistry is, in general, a patentable subject area. But it is so diverse and there is always so much to learn. Being involved in patent law gives me a unique perspective on new technologies and the use of chemistry in those new technologies. For example, over the years I have learnt about fungicidal glue line treatments of wood, grass endophytes, the world of pharmaceuticals, mastitis treatments, the use of various milk proteins in food products, and catheter technology, just to name a few. I have been able to liaise with clients from around the world and immerse myself in their world of science and what they are passionate about.
What problems are you solving in your day-to-day role?
Now that I am involved in litigation, problem solving involves understanding the science and formulating legal arguments to present the science in a way that best serves our client’s purposes. It is about understanding the background art, the new technology and how it is, or is not, a development on what existed before. This requires a close working relationship with the client, the ability to ask pointed questions to fully understand the matter and the ability to do further research to fill in gaps in knowledge.
Science is all about investigating something new. This need to investigate is a huge part of successful litigation – if you don’t fully understand the underlying science, there is no way you can represent your client successfully.
Celebrating International Day of Women and Girls in Science.
Did you know, our talented people aren’t just experts in the legal field. Many of them have also studied other subjects, such as science. While our people are experts in law, their in-depth scientific knowledge allows them to work closely with researchers in the public and private sectors to protect and commercialise innovation. Whether it be developing a new drug, a medical device, or plant variety, IP plays an important role in protecting these innovations and getting them to market.
To celebrate International Day of Women and Girls in Science, we spoke to Dr Nikki Templeton, Dr Briar Dominick and Dr Victoria Argyle who work at the intersection of science and law. All three have PhDs in scientific subjects and these women continue to make waves in the world of IP.

Why did you choose a career in science?
I always liked understanding how things work and why, especially the human body. I didn’t want to be a medical doctor, but loved studying human biology at school. Medical research was the area that drew my interest, and I was fascinated by how the brain was involved in so many complex processes. After finishing my PhD, I spent a few years working as a postdoctoral researcher, where I was involved in researching new therapeutics for multiple sclerosis. I loved the hands on work in a lab, but wanted to move out of academia so I joined AJ Park in 2020 as a patent executive.
Science is always changing and advancing, and I love that.
What do you enjoy most about your job?
I enjoy the process of being given a new area of science to work on from a patent perspective and having to quickly research and understand the background information and the scientific advancements that have been made. Science is always changing and advancing, and I love that. I also enjoy talking to clients about their inventions and research.
Why should girls and women consider a career in science?
You get to develop and use a huge range of skills - communication, hands on research, teaching, and critical thinking to name a few. These are skills that you can use in all parts of your life. Every day is different and making new discoveries or answering your research questions can be really satisfying.

Why did you choose a career in science?
I always enjoyed science at high school and it always “clicked” for me. I kept my options open for as long as possible at university and ended up studying a mixture of chemistry, pharmacology and biochemistry because that’s what interested me.
I worked a summer in a biofuel lab and nine months in a lab at a winery before starting my PhD. After that, I worked at the University of Auckland researching and teaching for three years before moving to AJ Park.
I get to see the broad range of research in
New Zealand and around the world and have a small part of it.
What do you enjoy most about your job?
I get to see the broad range of research happening in New Zealand and around the world and have a small part of it. The amount of innovation in this space is amazing, and it’s great to be able to support clients all over the world to protect and commercialise their important work.
What problems are you solving in your day-to-day role?
A phenomenal amount of work goes into researching and developing things that improve our lives. I help clients commercialise and protect their research in areas such as pharmaceuticals, food science, and biodegradable materials.
Why should girls and women consider a career in science?
Science affects everyone and everything. If you’re truly interested in science and solving the critical problems we face all over the world, then a career in science is for you.

Why did you choose a career in science?
My first chemistry teacher at Katikati College was a key reason I pursued chemistry at University. He recognised my ability in the subject and encouraged me to take it further after high school. However, I also loved history, English, and economics and, according to the careers book Katikati College produced, all three would be useful in the field of law.
I landed on studying law and science and during University I attended a seminar about a career as a patent attorney. I realised very quickly that this career would be the perfect opportunity for me to combine both my law and chemistry studies in the real world. It was also very clear to me that my science background was more impressive than my law background – one can be a patent attorney without ever studying law at University.
I am now a qualified patent attorney and employed as a senior associate in the litigation team at AJ Park. My science background means I am perfectly placed to assist in all patent-related litigious matters and I now find myself doing a lot of work for Fonterra. So, while my career in science was limited to my time at university, I have used my science knowledge throughout my career in law to assist clients in obtaining and maintaining/defending their patent rights.
I get to liaise with clients from around the world and immerse myself in their world of science and what they are passionate about.
What do you enjoy most about your job?
The fact that I am constantly learning about new areas of science. Chemistry is, in general, a patentable subject area. But it is so diverse and there is always so much to learn. Being involved in patent law gives me a unique perspective on new technologies and the use of chemistry in those new technologies. For example, over the years I have learnt about fungicidal glue line treatments of wood, grass endophytes, the world of pharmaceuticals, mastitis treatments, the use of various milk proteins in food products, and catheter technology, just to name a few. I have been able to liaise with clients from around the world and immerse myself in their world of science and what they are passionate about.
What problems are you solving in your day-to-day role?
Now that I am involved in litigation, problem solving involves understanding the science and formulating legal arguments to present the science in a way that best serves our client’s purposes. It is about understanding the background art, the new technology and how it is, or is not, a development on what existed before. This requires a close working relationship with the client, the ability to ask pointed questions to fully understand the matter and the ability to do further research to fill in gaps in knowledge.
Science is all about investigating something new. This need to investigate is a huge part of successful litigation – if you don’t fully understand the underlying science, there is no way you can represent your client successfully.